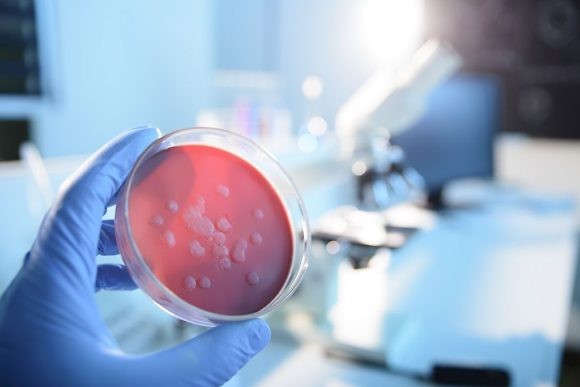
image

Gardnerella vaginalis — это биологический вид анаэробных бактерий, являющийся возбудителем гарднереллы, заболевания женской репродуктивной системы. Он заразен по происхождению, но не распространяется на заболевания, передающиеся половым путем (инфекции, передающиеся половым путем). В небольшом количестве (не более 1% всех микроорганизмов) гарднерелла постоянно присутствует в женском организме (влагалище и уретра), но при активном размножении быстро разрушает нормальную микрофлору. В этом случае гарднерелла может стать причиной развития не только гарднереллеза, но также кандидоза и других заболеваний репродуктивной системы.
Основные причины развития гарднереллеза
Развитие гарднереллеза происходит в результате изменения состава микроцветов, когда количество полезных микроорганизмов (лактобацилл) уменьшается и условно увеличивается количество патогенных (гарднереллез). Этот дисбаланс может быть вызван следующими причинами.
Инфекции
Гарднереллез — заболевание, которое может появиться на фоне заболеваний, передающихся половым путем: гонореи, хламидиоза, трихомониаза. Размножение гарднереллы провоцирует воспаление слизистой оболочки, нарушение микрофлоры и, если не лечить, развитие бесплодия. Важно отметить, что гарднереллы, как правило, в мужском организме не задерживаются, но в 10% случаев могут сделать мужчину носителем (при незащищенном половом акте).
Гормональный дисбаланс
Этот сбой может быть вызван, например, беременностью. Как и молочница, здесь часто встречается гарднереллез. Другими провоцирующими факторами являются сильный стресс, прием лекарств (в том числе противозачаточных и антибиотиков), наличие ряда заболеваний. Чтобы установить точную причину, требуется консультация специалиста.
Эндокринные расстройства
Частый случай — гарднереллез на фоне сахарного диабета. При повышенном уровне сахара в крови может нарушиться щелочной баланс слизистой оболочки влагалища, что приведет к развитию патогенной микрофлоры.
Общая интоксикация организма
Спровоцировать развитие гарднереллеза может даже обычное пищевое отравление, которое приводит к дисбактериозу влагалища и кишечника.
Резкое снижение иммунитета
Это состояние может быть связано как с внутренними причинами (например, заболевание крови, костного мозга и так далее), так и с внешними факторами (резкая смена климатических условий, радиация и т.д.).
Симптомы гарднереллеза
Незначительное изменение микрофлоры влагалища обычно остается для женщины незамеченным. Гарднереллез, переходящий в хроническую форму, протекает бессимптомно. В острой форме сопровождается неприятными ощущениями во влагалище, включая зуд, жжение, боль. Также женщина может заметить увеличение количества выделений, изменение их цвета, текстуры и запаха, которые могут не исчезнуть даже после водных процедур. Многие инфекционные заболевания мочеполовой системы, в том числе гарднереллез, имеют схожие симптомы, поэтому для их дифференциации необходимо обратиться за консультацией к специалисту.
Лечение гарднереллеза
Лечение гарднереллеза назначает гинеколог. Врач, прежде всего, выясняет точную причину патологического размножения бактерий. Если гарднереллез развивается на фоне заболевания, передающегося половым путем, лечение женщины в основном будет направлено на его устранение. Основная цель — снизить количество гарднерелл за счет приема антибиотиков, которые могут быть назначены в виде таблеток, принимаемых внутрь, а также вагинальных таблеток или суппозиториев. Следующей мерой может быть вагинальное орошение антибактериальными растворами. Следующим шагом обычно является использование лекарств для заселения микрофлоры полезными бактериями. После восстановления нормального баланса неприятные симптомы должны исчезнуть.
Чтобы записаться на консультацию к гинекологу, звоните по телефону +7 (495) 223-38-83 с 9.00 до 21.00.
Гарднереллез у женщин – симптомы и лечение

Нарушение баланса микрофлоры дает возможность колониям условно-патогенных бактерий и грибов разрастаться. В этом случае развивается бактериальный вагиноз. Бактериальный вагиноз часто называют гарднереллой, так как обычно во влагалище начинают активно размножаться бактерии Gardnerella vaginalis, вытесняя нормальную микрофлору.
Что такое гарднереллез
Гарднереллез часто ошибочно считают инфекцией, передающейся половым путем (ИППП). Действительно, причиной гарднереллеза, как и любого другого бактериального вагиноза, является сильный дисбаланс микрофлоры влагалища, в результате чего количество лактобацилл в микросреде влагалища значительно уменьшается, а количество условно-патогенной флоры, такой как гарднерелла, увеличивается по сравнению с к норме. Микоплазма, уреаплазма, стрептококки и др. они также могут вызвать бактериальный вагиноз.
Бактериальный вагиноз — одно из наиболее распространенных заболеваний влагалища у женщин от полового созревания до менопаузы, с оценочной распространенностью от 5 до 70%. При этом гарднереллу можно обнаружить почти у 50% всех женщин даже при отсутствии симптомов бактериального вагиноза.
Гарднерелла прикрепляется к поверхности эпителия влагалища, после чего начинается выброс токсичных биологических продуктов. Наличие гарднереллы в большом количестве подщелачивает кислую среду влагалища и тем самым создает условия для прикрепления других бактерий и грибков. При запущенных формах гарднереллеза у женщин развиваются воспалительные заболевания влагалища, матки и придатков.
Бактериальный вагиноз может вызвать бесплодие и осложнения во время беременности. У мужчин гарднереллез чаще протекает бессимптомно, хотя в некоторых случаях он вызывает воспаление мочевыводящих путей, простаты, яичек и даже может вызвать бесплодие.
Симптомы и лечение гарднереллеза будут зависеть от состояния вашего организма, стадии заболевания и наличия или отсутствия сопутствующей инфекции. Если у вас есть какие-либо подозрительные симптомы, вам следует обратиться к врачу, который поставит диагноз и поможет выбрать лекарства. Необходимо вылечить это заболевание.
Гарднереллез у женщин: причины возникновения
Не только бактерии одного вида участвуют в патогенезе бактериального вагиноза у женщин. У большинства пациентов с диагнозом бактериальный вагиноз развивается не только гарднереллез, но и микоплазмоз, уреаплазмоз и т.д. При неблагоприятных условиях, модифицирующих микрофлору влагалища, условно-патогенные и патогенные микроорганизмы создают комфортные условия для роста, благодаря чему образуются специфические полимикробные ассоциации. Бактериальный вагиноз часто «сочетается» с кандидозом, вызываемым дрожжеподобными грибами. Этот возбудитель обнаруживается в мазке, как правило, с высоким титром в сочетании с увеличением количества анаэробных бактерий и гарднерелл при явном дефиците или даже полном отсутствии лактобацилл. К сожалению, назначение лактобацилл не показывает прямой связи с состоянием интимной микрофлоры, поэтому восстановление здоровой среды — сложный процесс.
Изучая интимные привычки и особенности половой жизни пациенток, врач может отметить наличие сопутствующих заболеваний, как гинекологических, так и других. Пациенты часто говорят о наличии нескольких сексуальных партнеров одновременно, о начале половой жизни в подростковом возрасте и о частой смене партнеров. В процессе сбора анамнеза также могут появиться сведения о многочисленных беременностях, закончившихся абортом, а также о различных инфекциях, передающихся половым путем. Нельзя утверждать, что существует прямая связь между развитием гарднереллеза у женщины и наличием возбудителя у ее полового партнера: результаты исследований показали, что только четверть обследованных мужчин имели микроорганизмы, идентичные тем, которые вызвали заболевание у женщины их партнеры.
Диагностика гарднереллеза
Диагностика гарднереллеза обычно не составляет труда. Врач собирает анамнез и жалобы пациента, проводит общий осмотр. Типичные жалобы при гарднереллезе — обильные сероватые выделения с «рыбным запахом». Кроме того, проводится анализ на кислотность влагалища, которая в норме колеблется от 3,8 до 4,5, и делается мазок на микрофлору влагалища. Гиперчувствительные тесты типа ПЦР не проводятся для диагностики вагиноза. Также больного обследуют на предмет наличия нарушения микрофлоры кишечника.
Гарднереллез у женщин: симптомы и лечение
Основная жалоба пациента — обильные белые или сероватые выделения из половых путей, часто с неприятным «рыбным» запахом. Дискомфорт и симптомы ухудшаются во время менструации и полового акта. Когда процесс запускается без надлежащего лечения, выделения приобретают желтовато-зеленый цвет, становятся более густыми, липкими и равномерно распределяются по стенкам влагалища. Жалобы на зуд и нарушение мочеиспускания у женщин могут отсутствовать или появляться лишь периодически. У женщин бактериальный вагиноз может вызвать обильное менструальное кровотечение, вызывающее боли внизу живота. Однако некоторые женщины не проявляют никаких симптомов болезни, а также субъективных ощущений. При постановке диагноза врач должен выяснить, лечился ли пациент антибиотиками, есть ли у него другие гинекологические или эндокринные нарушения, поинтересоваться, как проводится интимная гигиена и каковы особенности сексуальной практики, в том числе выбор противозачаточных средств. Стандартная схема лечения гарднереллеза включает антибактериальные препараты местного и системного действия, а также метронидазол. Этот препарат можно применять только с учетом противопоказаний, к которым относятся беременность и период лактации, заболевания крови, органические нарушения нервной системы. Метронидазол нельзя сочетать с алкоголем во время лечения и через сутки после его прекращения. Антибактериальные препараты показаны в случаях, когда гарднереллез связан с заболеваниями, передающимися половым путем.
Микробные биопленки как способ бактерий уклониться от воздействия лекарств
Когда экосистема влагалища нарушена, «вредные» бактерии начинают быстро размножаться и активно обмениваться информацией, а затем «прикрепляются», образуя хорошо структурированную полимикробную пленку, покрывающую эпителий влагалища. При дальнейшем распространении инфекции также могут обнаруживаться бактериальные пленки на внутренней слизистой оболочке матки (эндометрии). Из-за образования микробных биопленок повышается устойчивость (резистентность) бактерий к антимикробным препаратам, что может вызывать хронические воспалительные процессы, снижать эффективность лечения и приводить к частым рецидивам вагиноза.
Образование биопленок приводит к нарушению репродуктивной функции у женщин, неудачным попыткам ЭКО, осложнениям и неблагоприятным исходам беременности ii. Устойчивость биопленки к классическим антимикробным препаратам обеспечивается за счет повышенной выработки специальных белков, препятствующих попаданию инородных частиц в клетку. В то же время биопленки представляют собой механический барьер, препятствующий проникновению лекарства. Для нейтрализации этого эффекта желательно использовать комбинацию антибактериальных препаратов и иммуномодулятора, способного предотвратить образование патологических биопленок. В чем еще опасность гарднереллеза? — Размноженные бактерии выделяют большое количество токсинов, борьба с которыми создает дополнительную нагрузку на организм. Разрастание гарднереллы подавляет клеточные механизмы иммунитета. По разным причинам силы иммунитета может быть недостаточно для борьбы с инфекцией.
Схема лечения гарднереллеза у женщин
Кислая среда влагалища защищает его от вирусов, бактерий и грибков, но при бактериальном вагинозе pH смещается в щелочную сторону, создавая благоприятную среду для присоединения других инфекций, например трихомонад, гонококковых или хламидийных инфекций. Кроме того, бактериальный вагиноз снижает показатели местного иммунитета и часто сопровождается синдромом местного приобретенного иммунодефицита. [1] В связи с этим специалисты рекомендуют как можно скорее провести комплексное обследование и лечение, так как постоянно «курящая» инфекция Gardnerella способствует прикреплению других возбудителей болезней и развитию воспалительных заболеваний органов малого таза.
Основу стандартной схемы лечения бактериального вагиноза составляют препараты местного антибактериального или антисептического действия. Однако способность бактерий образовывать микробные биопленки приводит к тому, что бактерии развивают большую устойчивость к противомикробным препаратам. Этому способствует самостоятельное применение женщинами антибактериальных препаратов без наблюдения врача. В результате болезнь сложно вылечить полностью, а при нарушении баланса микрофлоры она вернется.
Еще одна важная причина рецидива бактериального вагиноза у женщин — снижение общего или местного иммунитета (нанесенного на слизистую влагалища). В здоровой среде специфические клетки, выстилающие вагинальный эпителий, действуют как надежный барьер для проникновения микробов. Естественный барьер предотвращает прямое взаимодействие микробов с клетками влагалища. Ослабление иммунитета способствует росту патогенной микрофлоры. Иммунная защита строится в основном за счет специальных белков — интерферонов, которые относятся как к системным, так и к местным факторам врожденного иммунитета. При частых рецидивах заболевания гинеколог может подсказать схему лечения, в которой наряду с противомикробными и антисептическими препаратами будут использоваться иммуномодулирующие средства, такие как свечи ВИФЕРОН. Согласно инструкции по применению, показаниями к назначению ВИФЕРОНА являются: инфекционно-воспалительные заболевания урогенитального тракта (хламидиоз, цитомегаловирусная инфекция, гарднереллез, бактериальный вагиноз, рецидивирующий кандидоз влагалища, микоплазмоз) в составе комплексной терапии. Действующее действующее вещество суппозиториев интерферон альфа-2b в сочетании с антиоксидантами оказывает системное действие на организм, повышая сопротивляемость инфекциям. В 2019 году Российское общество акушеров и гинекологов (РОАГ) рекомендовало включение ВИФЕРОНА 500 000 МЕ (2 раза в день в течение 10 дней) в комплексную терапию бактериального вагиноза [1]
Гарднереллез у мужчин: симптомы и лечение
Мужское здоровье — тема, требующая отдельного рассмотрения. В отличие от женщин, гарднерелла у мужчин является инфекционным заболеванием, поскольку гарднерелла не является характерной флорой для мужского организма. Заражение происходит половым путем, развитию болезни у мужчин способствует снижение иммунитета, наличие других заболеваний мочеполовой системы или заболеваний, передающихся половым путем, прием определенных лекарств и наличие большого количества половых партнеров. Большинство мужчин переносят заболевание бессимптомно, однако в ряде случаев наблюдаются симптомы уретрита, основными симптомами которого являются серые водянистые выделения с неприятным запахом из уретры, зуд, жжение и дискомфорт при мочеиспускании. Осложнениями гарднереллеза у мужчин могут быть воспаления простаты, мочевого пузыря, почек и других органов мочеполовой системы.
Подготовка к беременности вместе с ВИФЕРОН
На этапе прегравидарной подготовки (подготовки к беременности) необходимо скорректировать нарушения микрофлоры влагалища, чтобы снизить вероятность развития осложнений, связанных с имеющимися инфекциями, и снизить риск новых инфекций во время беременности.
Учитывая значительную роль иммунитета слизистых оболочек половых путей в механизмах рецидива инфекции, важно назначать такие препараты, как ВИФЕРОН, способный корректировать на уровне иммунорегуляторных клеточных субпопуляций и нормализовать местную иммунореактивность клеток. [3,4]. Повышение местного иммунитета слизистой оболочки влагалища и всей мочеполовой системы способствует достижению более устойчивых результатов в борьбе с инфекциями. Исследования показали, что использование суппозиториев ВИФЕРОН в комплексной терапии бактериального вагиноза на этапе прегравидарной подготовки привело к эффективному результату в виде стойкой клинико-лабораторной ремиссии [5].
Справочные материалы
Автор статьи
Общий практик
- Гинекология: национальные рекомендации / под ред. Савельева Г.М., Сухих Г.Т., Серова В.Н., Манухин И.Б., Радзинский В.Е. — 2-е изд., Перераб. И доп. — М .: ГЭОТАР-Медиа — 2019 — 1008 с.
- Хрянин А.А. Бактериальный вагиноз: в ногу со временем. Современные представления о рациональной терапии бактериального вагиноза. // Регистр StatusPreasens. — 2017. — №1. — С.53-65..
- Возможность прегравидарной подготовки // Коррекция микробиоценоза влагалища — Издательство Статус Praesens profmedia
- Ранняя беременность. От прегравидарной подготовки к здоровому вынашиванию / под ред. Радзинский В.Е., Оразмурадова А.А. — 3-е изд., Перераб. И доп. — М .: Редактор журнала StatusPreasens. — 2018. — 800 с.
- Тапильская Н.И., Шахова М.А. Предбеременная подготовка супружеской пары с участием обоих партнеров с частыми рецидивами бактериального вагиноза // Лечащий врач. — 2018. — №2. — С. 82-87.